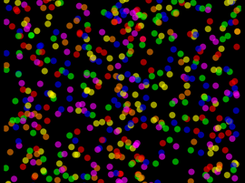
Game Start

Google Group (gmail account) Signup: https://groups.google.com/u/6/g/chainreactionbetagroup
Please sign up at the homepage listed above and send app feedback through the app interface to support free software being released on the Google Play Store!
Follow Android ChainReaction
Other Useful Business Software
Build Agents and Models on One Platform
Gemini Enterprise Agent Platform is Google Cloud's comprehensive platform for developers to build, scale, govern, and optimize agents and models. Choose from Google's most advanced models and third-party models like Anthropic's Claude Model Family.
Rate This Project
Login To Rate This Project
User Reviews
Be the first to post a review of Android ChainReaction!